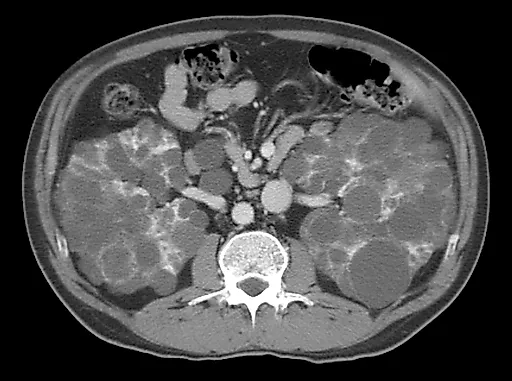
Диагностика объемных образований почек

Обследование больного
Обследование больного
На первых этапах обследования урологического больного большое значение имеют общеклинические методы исследования (опрос, осмотр, пальпация, перкуссия).
Выявляют жалобы больного, анамнез заболевания и жизни, перенесенные заболевания, наследственность. Наиболее часто люди, страдающие заболеваниями органов мочевой системы, жалуются на боли в пояснице. Важно выяснить характер боли, ее локализацию, иррадиацию, причину возникновения. Боли могут быть острыми или тупыми.
Боли в области почки и мочеточника возникают в основном при почечных заболеваниях. Они обычно распространяются вниз по ходу мочеточника и ниже в область половых органов, паха, внутренней поверхности бедра.
Диагностика объемных образований почек
Субъективные симптомы, такие как боль, гематурия и пальпируемая опухоль в поясничной области, являют...
Статья
Эндоскопические методы исследования
Наиболее часто катетеризация мочевого пузыря применяется для выявления инфекции мочевыводящих путей...
Статья
Нейрогенный мочевой пузырь
Автономная нервная система состоит из симпатической и парасимпатической нервных систем. Парасимпатич...
Статья
Ультразвуковое исследование
Чем выше частота ультразвуковой волны, тем меньше глубина проникновения в ткань и лучше разрешение б...
Статья
Диагностика почечной недостаточности
Острую почечную недостаточность (ОПН) можно определить как внезапное снижение функции почек. Степень...
Статья